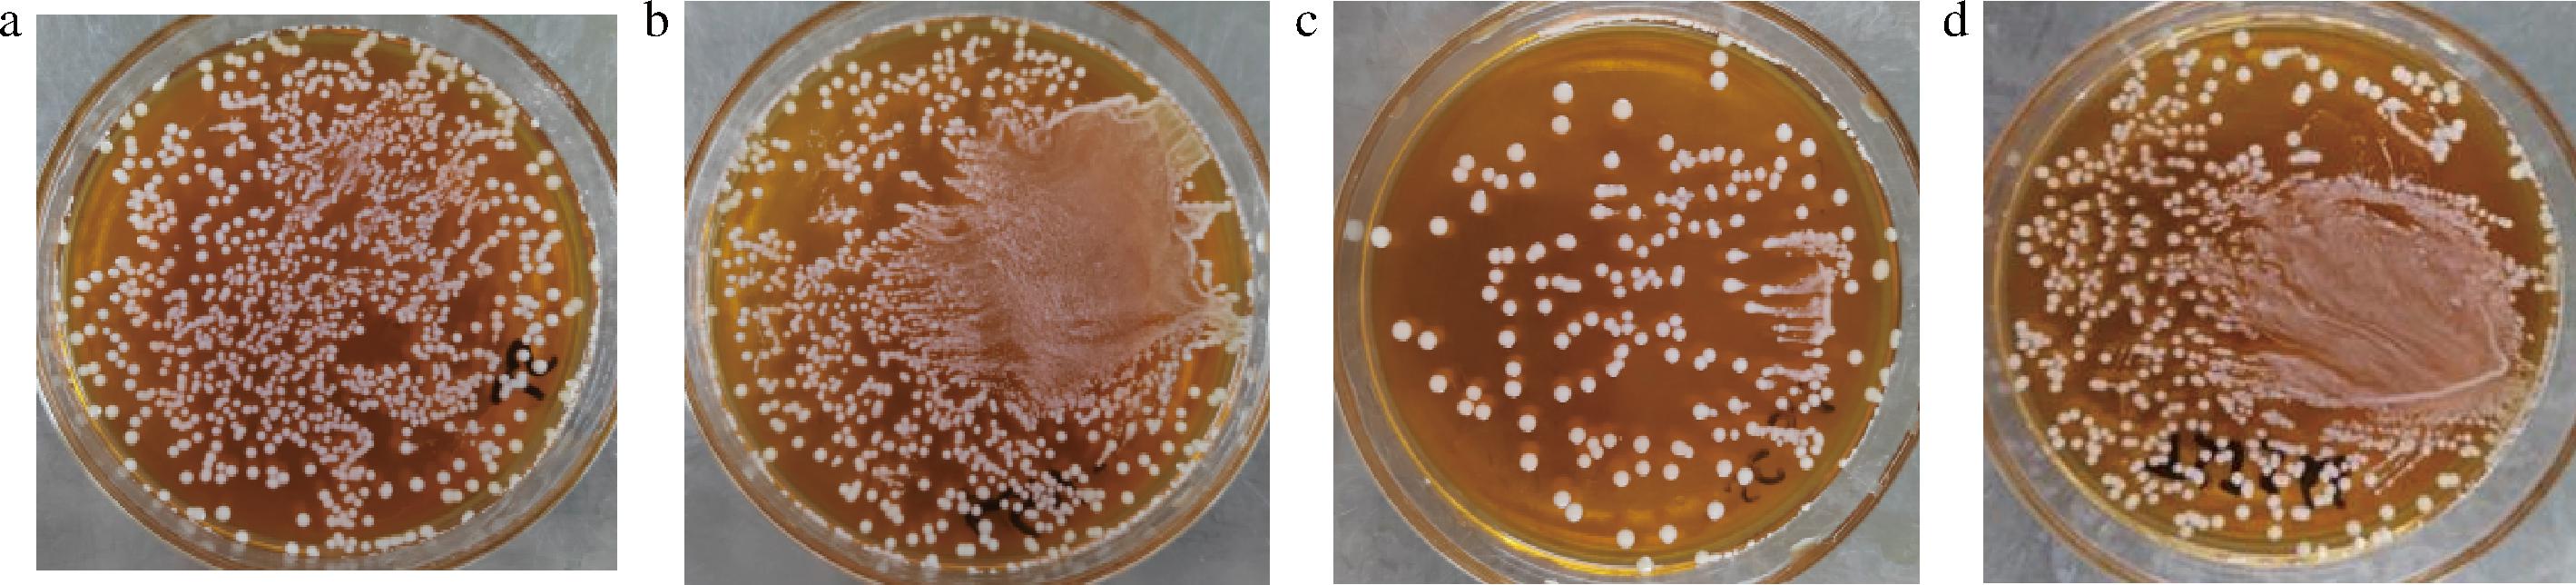

乳酸菌是一类可发酵碳水化合物产生乳酸的革兰氏阳性菌,具有丰富的物种多样性和广泛的生态环境分布,在食品、生物医学及农业领域应用价值显著,其绝大部分是人体内具有重要生理功能的微生物菌群。乳酸菌能促进动物生长、改善胃肠道功能、降低血清胆固醇、改善食品风味口感、抗癌抗炎、提高机体免疫力等[1-3]。乳酸菌的益生效应与其代谢产物密切相关,其中胞外多糖(exopolysaccharides,EPS)作为关键次级代谢产物,通过参与菌体环境适应性与宿主互作,已成为功能特性挖掘的重要靶点。
EPS是微生物在生长繁殖过程中分泌到发酵液中,易于纯化分离的一类水溶性的高分子多糖聚合物,可分为同多糖和杂多糖,前者由单糖组成,后者则由2种或以上单糖构成,属于微生物生长的次级代谢物[4]。EPS能够保护菌体自身抵御渗透压和拮抗物等不利条件,同时还具有抗氧化作用、降低胆固醇、调节肠道菌群、抗肿瘤及多种免疫调节功能[5],其安全性和功能特异性使得植物乳植杆菌及其所产EPS在功能性食品、化妆品和生物医药领域具有巨大的应用潜力[6]。
传统发酵食品是天然微生物资源库,蕴含大量具备环境适应性与功能潜力的乳酸菌。产EPS益生菌的筛选来源广泛,比如变质啤酒、三地羊肚菌菌丝、东北酸菜等;其中对于产EPS植物乳植杆菌的报道也较多,黄承敏等[7]从自然发酵剁辣椒中分离筛选出一株高产EPS的植物乳植杆菌并对产糖条件进行了发酵优化;檀茜倩等[8]从传统发酵食品泡菜中筛选出一株产EPS植物乳植杆菌并对其益生特性等进行了分析。西北地区饮食文化孕育了浆水、酸菜、酸乳、兰州老酸奶等特色发酵食品,其菌群结构具有鲜明特性,然而,当前针对该区域发酵食品中产EPS乳酸菌的系统筛选、益生特性综合评价的研究不足,限制了高附加值产品的开发。本研究旨在挖掘西北特色发酵食品资源中兼具优良益生特性与高效EPS合成能力的乳酸菌菌株,为产EPS乳酸菌资源的开发利用提供菌种资源与理论基础,同时深化对植物乳植杆菌等菌种功能多样性的认知。
1 材料与方法
1.1 材料与试剂
陇南浆水、老酸奶、酸菜、天水浆水,成品购自甘肃省兰州市大润发超市;MRS肉汤、MRS琼脂,海博生物技术有限公司;NaCl、乙醇、三氯乙酸、苯酚、H2SO4,甘肃康灵生物科技有限公司;MgSO4·7H2O、可溶性淀粉、卢哥式碘液、药敏试纸、FeSO4、铁氰化钾、FeCl3,城关区白银路柏瑞泰实验器材经营部;胃蛋白酶、胰蛋白酶、8 000~14 000 kDa透析袋,北京索莱宝科技有限公司;四环素(30 μg/片)、卡那霉素(30 μg/片)、氨苄西林(10 μg/片)、庆大霉素(10 μg/片)、红霉素(15 μg/片)、氯霉素(30 μg/片)、克林霉素(2 μg/片)、万古霉素(30 μg/片),上海麦克林生化科技股份有限公司;DPPH、PBS、ABTS溶液、哥伦比亚血琼脂平板,青岛海博生物科技有限公司。其他实验所用试剂均为分析纯。大肠埃希氏菌(Escherichia coli) CMCC(B) 44102、北京棒杆菌(Corynebacterium pekinense) AS1.295、枯草芽孢杆菌(Bacillus subtilis) CMCC(B) 63501、金黄色葡萄球菌(Staphylococcus aureus)ATCC6538,中国工业微生物菌种保藏中心。
1.2 仪器与设备
WB20水浴锅,英帝克(江苏)生物科技有限公司;KH22R高速冷冻离心机,湖南凯达科学仪器有限公司;电子天平,上海精密科学仪器有限公司;L6紫外-可见分光光度计,上海科晓科学仪器有限公司;LDZM-60L-Ⅰ立式高压蒸汽灭菌器,上海申安医疗器械厂;VS-1300-U操作工作台,中国苏州智净净化设备有限公司;恒温培养箱,无锡玛瑞特科技有限公司;PHS-25型pH计,上海雷磁仪器厂。
1.3 实验方法
1.3.1 菌株的筛选
参考黄承敏等[7]的方法并做修改,采用稀释涂布法,取发酵食品(陇南浆水、老酸奶、酸菜、天水浆水)1 mL,加入无菌生理盐水,涡旋混匀并制备梯度稀释液,吸取稀释液涂布MRS固体培养基,37 ℃培养48 h,观察并记录菌落特征,用无菌移液枪头轻轻挑起单菌落,观察有无连续的拉丝,将有拉丝的单菌落挑取划线至MRS平板上进行纯化,单菌落进行保存;采用TCA法去除蛋白质和提纯法制备粗EPS。
1.3.2 EPS的提取及测定
以葡萄糖质量浓度(x)为横坐标,吸光度值(y)为纵坐标,绘制葡萄糖标准曲线回归方程为:y=0.004 3x+0.015 7,其决定系数R2为0.999 3。采用苯酚-硫酸法结合葡萄糖标准曲线回归方程计算EPS产量。
1.3.3 菌株的形态学和生理生化鉴定
选取单菌落进行革兰氏染色后镜检观察其颜色、形状及有无芽孢。生理生化实验包括酯酶水解实验、明胶液化实验、甲基红实验、糖发酵实验、淀粉水解实验、吲哚产生实验和柠檬酸盐利用实验。
1.3.4 分子生物学鉴定
将纯化后得到的菌株送至生工生物工程(上海)股份有限公司,利用细菌16S rDNA序列测序的方法对细菌进行种属鉴定,包括细菌基因组DNA提取、16S rDNA特异引物PCR扩增与纯化、DNA测序、序列比对等步骤,测定后的结果登陆美国国家生物技术信息中心(National Center for Biotechnology Information,NCBI)进行BLAST比对,采用MEGA软件构建系统发育树,确定菌种的种属[9]。
1.3.5 菌株生长曲线与产酸能力的测定
将菌株活化后按2%接种量接入150 mL MRS肉汤培养基中,37 ℃培养24 h,期间每隔2 h测定OD600值,以未接菌的培养基作为空白对照组,绘制菌株生长曲线,期间每隔2 h测其pH值[10]。参考SADEGHI等[11]的方法取样滴定并计算产酸量(以乳酸计)。
1.3.6 菌株的自聚集、共聚集能力和表明疏水性
自聚集实验参考KIM等[12]的方法;共聚集实验参考LIN等[13]的方法;参考ADESULU-DAHUNSI等[14]的方法检测菌株的表面疏水性。
1.3.7 菌株的胆盐和人工胃肠液耐受性
胆盐耐受性实验和人工胃肠液耐受性实验参考徐晶晶等[15]的方法。
1.3.8 菌株的抗生素敏感性实验
采用纸片扩散(Kirby-Bauer,K-B)[16]法检测菌株对抗生素的敏感性,将菌株按体积分数0.2%接种至MRS培养基中,待平板凝固后,用无菌镊子将抗生素纸片在无菌条件下均匀放置在平板上。37 ℃培养24 h后测量抑菌圈直径。
1.3.9 菌株的溶血性试验
配制200 mL哥伦比亚血琼脂培养基,灭菌后待其温度降至45~50 ℃,加入5%(体积分数)无菌脱纤维羊血混匀;培养基凝固后活化菌株划线于37 ℃培养48 h,同时以未接菌的空白哥伦比亚血琼脂培养基为空白对照[16]。
1.3.10 菌株的抑菌能力
参考檀茜倩等[8]的方法,采用双层平板法检测菌株的抑菌能力。
1.3.11 菌株的体外抗氧化能力
参考HU等[17]的方法测定菌株发酵上清液和细胞破碎提取物的DPPH自由基清除能力和羟自由基清除能力;参考谢林林等[18]的方法测定菌株发酵上清液和细胞破碎提取物的ABTS阳离子自由基清除能力和还原能力。
1.4 数据统计分析
实验所得数据为3次重复实验结果的平均值;数据采用SPSS 软件进行差异显著性分析;采用Origin 2019进行差异显著性分析并绘图。
2 结果与分析
2.1 产EPS菌株的筛选
从4种发酵食品中各筛选一株产EPS的乳酸菌,分别命名为:天水浆水(TSJS)、老酸奶(LSN)、陇南浆水(JS)、酸菜(SC),37 ℃培养48 h,观察并记录菌落特征。用无菌移液枪头轻轻挑起单菌落,将有拉丝的单菌落挑取划线至MRS固体培养基上,连续划线培养3代,得到其单菌落均呈圆形,边缘整齐,直径约为2 mm,颜色为乳白色,表面光滑,不透明,凸起,与檀茜倩等[8]的筛选结果一致,实验结果如图1所示。
a-JS;b-LSN;c-SC;d-TSJS
图1 菌株的菌落形态
Fig.1 The colony morphology of the strains
2.2 菌株的鉴定
2.2.1 菌株的形态学鉴定
对单菌落进行革兰氏染色后,在100倍油镜下观察,如图2所示,其均被染成蓝紫色,单细胞呈杆状,形成聚集排列,均为革兰氏阳性菌,与徐晶晶等[15]的革兰氏染色结果一致。

a-JS;b-LSN;c-SC;d-TSJS
图2 菌株的形态学结果
Fig.2 The morphological results of the strains
2.2.2 菌株的生理生化鉴定
如表1所示,菌株TSJS、LSN、JS、SC的生理生化实验结果与乳植杆菌属相近[18],结合其形态学特征,初步确定菌株TSJS、LSN、JS、SC为乳植杆菌属。
表1 菌株的生理生化实验结果
Table 1 The physiological and biochemical experimental results of the strains

实验项目TSJSLSNJSSC酯酶水解实验++++甲基红实验++++淀粉水解实验++++吲哚产生实验++++明胶液化实验----糖发酵实验++++柠檬酸盐利用实验----
注:‘+’表示阳性,‘-’表示阴性。
2.2.3 菌株的分子生物学鉴定
测序结果显示,菌株JS、LSN、SC、TSJS的16S rDNA序列长度分别为1 528、1 531、1 529、1 529 bp。基于16S rRNA测序结果构建菌株JS、LSN、SC、TSJS的系统发育树,比对覆盖多个染色体区域,结果如图3所示。4株菌被鉴定为Lactiplantibacillus(乳植杆菌属),分别命名为Lactiplantibacillus plantarum JS、Lactiplantibacillus plantarum LSN、Lactiplantibacillus plantarum SC、Lactiplantibacillus plantarum TSJS。

a-JS;b-LSN;c-SC;d-TSJS
图3 基于16S rDNA序列构建的菌株系统发育树
Fig.3 Phylogenetic tree of the strains constructed based on 16S rDNA sequences
2.3 EPS含量的测定
4株菌按5%接种量,37 ℃发酵48 h,采用苯酚-硫酸法[8]测定得到JS-EPS、LSN-EPS、SC-EPS、TSJS-EPS产量分别为0.282、0.208、0.215、0.230 mg/mL。
2.4 菌株的生长特性
如图4-a显示,菌株L.plantarum JS、L.plantarum LSN、L.plantarum SC、L.plantarum TSJS,在0~12 h期间呈上升趋势,并在2~12 h期间迅速增长,在12~24 h期间趋于平缓,后呈现下降。如图4-b所示,在0~18 h期间菌液pH均呈下降趋势,并在2~8 h期间迅速下降,在12~24 h期间趋于平缓,最终稳定在3.8左右,说明在此期间菌株持续地产生乳酸并不断积累,证明了这4株菌的产酸能力良好。产酸能力是菌株活力的重要体现,以筛选出来的L.plantarum LSN、L.plantarum SC、L.plantarum TSJS、L.plantarum JS作为出发菌株,测定其24 h内的总酸(以乳酸计)产量,结果如图4-c所示,这4株菌在发酵过程中均可产酸,且在24 h内L.plantarum JS的产酸能力最强。

a-生长曲线;b-pH变化;c-产酸能力
图4 菌株的生长特性
Fig.4 Growth characteristics of the strains
2.5 菌株的自聚集率、共聚集率和表面疏水性
乳酸菌的自聚集、共聚集和表面疏水性与细菌的黏附性存在一定的相关性,自聚集、共聚集和表面疏水性能力越高,其黏附性越好[18]。如表2所示,各菌株的自聚集率随着时间的延长而升高,在孵育6 h后,L.plantarum JS、L.plantarum LSN、L.plantarum SC、L.plantarum TSJS的自聚集率分别为(8.24±0.06)%、(8.36±0.06)%、(18.81±0.50)%和(10.46±0.71)%;由表3可知,共聚集能力在1 h最强,L.plantarum JS、L.plantarum LSN、L.plantarum SC、L.plantarum TSJS的共聚集率分别为(29.37±0.23)%、(33.41±0.00)%、(27.80±0.23)%和(37.05±0.71)%;表面疏水性分别为(93.85±3.00)%、(73.43±4.00)%、(43.09±4.00)%和(89.55±1.00)%。
表2 菌株的自聚集能力 单位:%
Table 2 Self-agglomeration ability of the strains

菌株孵育时间/h23456SC8.42±0.28a9.27±0.29a11.52±0.06a14.29±0.35a18.81±0.50aJS1.50±0.07c2.83±0.06c4.34±0.00c6.21±0.06d8.24±0.06cLSN2.93±0.07b4.51±0.06b4.67±0.01c7.42±0.06c8.36±0.06cTSJS0.34±0.07d4.14±0.17b5.07±0.22b9.72±0.42b10.46±0.71b
注:字母不同表示存在显著性差异(P<0.05)(下同)。
表3 菌株的共聚集能力 单位:%
Table 3 Co-agglomeration ability of the strains

菌株孵育时间/h0123456SC5.53±0.27b27.80±0.23d25.58±0.13a25.77±0.13a25.86±0.27d25.62±0.13c24.84±0.13bJS12.43±0.27a29.37±0.23c20.20±0.13b23.85±0.13b26.73±0.49c26.18±0.75b24.55±0.36bLSN0.81±0.23d33.41±0.00b19.91±0.23c21.38±0.54c27.59±0.47b26.04±0.59b23.86±0.00cTSJS4.30±0.16c37.05±0.71a16.90±0.13d17.83±0.75d31.01±0.36a30.78±0.13a29.53±0.23a
2.6 菌株的胆盐和人工胃肠液耐受性
食物通过胃的时间约1~3 h,通过小肠的时间约1.5 h,菌株的模拟胃肠液存活率一定程度上反映其经历消化后到达人体小肠的存活率,而对胆盐耐受性是益生菌在小肠中生长繁殖的基本条件之一[15]。为了评价菌株4株菌适应胃肠道环境的耐受能力,对其进行胆盐耐受性和人工模拟胃肠液耐受性试验分析,结果如图5所示。

a-胆盐耐受性;b-人工模拟胃液耐受性;c-人工模拟肠液耐受性
图5 菌株的胃肠道环境耐受能力
Fig.5 Gastrointestinal environment tolerance of the strains
当胆盐质量分数为0.3%时,L.plantarum JS的胆盐耐受性最高,存活率为(99.23±0.25)%,表现为较强的耐胆盐能力;L.plantarum SC的胆盐耐受性最低,存活率为(87.86±0.58)%。人工模拟胃液耐受性最高菌株为L.plantarum JS,存活率为(90.51±0.87)%,最低菌株为L.plantarum SC(76.34±0.69)%;人工模拟肠液耐受性最高菌株为L.plantarum LSN,存活率为(99.74±0.82)%,L.plantarum TSJS的人工模拟肠液耐受性最低,存活率为(96.26±0.58)%,结果证明这4株菌均能较好地适应胃肠道环境。
2.7 菌株的抗生素敏感性
如表4所示,4株菌均对四环素、卡那霉素、氨苄西林、庆大霉素、红霉素、氯霉素和克林霉素等7种常用抗生素敏感,表明其安全性较高;但是对万古霉素耐药,这种可能由点突变引起的耐药性是许多乳酸菌种类所固有的,并认为是安全的,这与徐晶晶等[15]和SALIBA等[19]的研究结果一致。
表4 菌株的抗生素敏感性
Table 4 Antibiotic sensitivity of the strains

抗生素抑菌圈直径/mmTSJSLSNSCJS四环素14.15±1.49 S 17.87±0.19 S 14.11±1.44 S 21.30±1.03 S 卡那霉素8.81±0.65 I 11.09±0.15 S 13.03±0.33 S 8.28±0.69 I 氨苄西林27.80±2.18 S 31.15±0.79 S 34.78±1.77 S 29.76±1.69 S 庆大霉素11.02±0.20 S 23.88±0.63 S 17.62±0.48 S 9.73±0.37 I 红霉素23.57±0.94 S 23.33±0.74 S 27.36±1.58 S 25.73±0.32 S 氯霉素20.08±0.18 S 24.55±0.58 S 20.77±1.33 S 25.29±0.68 S 克林霉素15.91±0.34 S 19.96±0.16 S 24.85±0.69 S 19.99±0.11 S 万古霉素 R
注:S表示细菌对该药物敏感;I表示敏感性中等;R表示细菌对该药物耐药。
2.8 溶血性实验
溶血实验的溶血现象分为α溶血、β溶血和γ溶血,其中α溶血又称草绿色溶血,即菌落周围形成草绿色半透明溶血环,直径为1~2 mm,是一种不完全溶血现象;β溶血则为完全溶血现象,菌落周围形成完全透明溶血环,直径为2~4 mm;γ溶血则为不溶血现象[10]。4株植物乳植杆菌的周围均无溶血圈,均为γ溶血,表明可以排除其具有溶血活性的致病风险;同时菌落处有轻微变黑现象,可能与机体血乳酸水平与溶血病情明显相关,推测该现象可能与菌株产酸能力较强引起乳酸堆积所致[15]。
2.9 菌株的抑菌能力
乳酸菌通过微生物代谢活动产生的代谢产物可以抑制某些致病菌的生长,因此抑菌能力也是评判益生菌的益生特性指标之一[20]。如表5所示,这4株植物乳植杆菌对4种致病菌具有不同程度的抑制活性。其中,L.plantarum LSN和L.plantarum SC对大肠埃希氏菌的抑制作用显著高于其他2株菌,而对北京棒杆菌的抑制作用明显低于其他菌株(P<0.05)。L.plantarum JS对于枯草芽孢杆菌的抑制作用是4株菌最强的。总体而言,本研究中的L.plantarum SC相较于其他3株菌对于4种病原指示菌具有较强的抑制作用。
表5 菌株的抑菌能力
Table 5 Antibacterial ability of the strains

菌株抑菌圈直径/mm大肠埃希氏菌北京棒杆菌枯草芽孢杆菌金黄色葡萄球菌JS10.36±0.88c12.12±0.26b15.36±0.65a11.32±0.43bLSN14.53±0.52a10.09±0.31c13.25±0.33c11.12±0.36bSC14.37±0.25a10.67±0.38c14.21±0.35b12.68±0.28aTSJS11.58±0.63b13.25±0.58a11.36±0.47d10.15±0.26c
2.10 菌株的体外抗氧化能力
如表6所示,4株菌的发酵上清液和细胞破碎提取物均表现出一定抗氧化能力。其中,L.plantarum LSN的发酵上清液DPPH自由基清除率最高为(79.23±1.15)%,显著高于其他3株菌(P<0.05)。ABTS阳离子自由基溶液呈蓝绿色,在734 nm波长处有较强吸收峰,抗氧化剂可以与ABTS阳离子自由基反应使其褪色,因此溶液吸光度可直观反映样品ABTS阳离子自由基清除能力[21]。L.plantarum JS的发酵上清液和细胞破碎提取物的ABTS阳离子自由基清除率最高分别为(82.61±0.00)%和(24.60±0.16)%,明显高于其他3株菌(P<0.05);L.plantarum LSN发酵上清液和L.plantarum TSJS细胞破碎提取物的羟自由基清除率最高分别为(94.70±0.27)%和(48.44±0.12)%,显著高于其他菌株(P<0.05);各菌株的发酵上清液还原能力均高于95%,而L.plantarum JS和L.plantarum TSJS的细胞破碎提取物还原能力依次是(25.62±1.28)%和(28.24±1.55)%。综合以上抗氧化活性测定结果,L.plantarum LSN的综合抗氧化能力显著高于其他3株菌;4株菌均具有良好的抗氧化能力,并且菌株发酵上清液的抗氧化能力均高于细胞破碎提取物,表明4株菌具有抗氧化能力的活性物质主要存在于其发酵液中,细胞破碎提取物中还原活性物质较少,结合本研究中EPS产量数据(0.208~0.282 mg/mL),表明其抗氧化活性主要源于分泌的EPS,这与LUO等[22]报道的植物乳植杆菌EPS清除自由基能力结果一致。未来将进一步结合Caco-2细胞氧化应激模型或小鼠实验,深入探究菌株及其EPS的体内抗氧化通路。
表6 菌株的体外抗氧化活性 单位:%
Table 6 In vitro antioxidant activity of the strains

项目SCJSLSNTSJSDPPH自由基发酵上清液71.43±1.08c71.01±1.12c79.23±1.15a72.11±1.00b细胞破碎提取物31.62±1.03b30.09±1.20c31.79±1.05b34.33±1.13a抗坏血酸 10mg/mL 94.81±1.0994.81±1.0994.81±1.0994.81±1.09ABTS阳离子自由基发酵上清液57.27±1.09d82.61±0.00a78.66±0.45c81.08±1.09b细胞破碎提取物15.81±1.18c24.60±1.16a15.60±1.00c20.76±1.18b抗坏血酸 10mg/mL 98.79±1.2498.79±1.2498.79±1.2498.79±1.24羟自由基发酵上清液58.85±1.35c82.19±1.05b94.70±1.27a83.58±1.10b细胞破碎提取物47.81±1.05b37.99±1.13c39.09±1.10c48.44±1.12a抗坏血酸 10mg/mL 96.02±1.0696.02±1.0696.02±1.0696.02±1.06还原能力发酵上清液96.84±1.02a96.68±1.04a96.94±1.02a95.85±1.00b细胞破碎提取物23.50±1.29c25.62±1.28b13.02±1.53d28.24±1.55a抗坏血酸 10mg/mL 96.47±1.0396.47±1.0396.47±1.1396.47±1.03
3 结论与讨论
本研究首次从西北传统发酵食品中筛选出4株产EPS的植物乳植杆菌新菌株,4株菌均表现出优良的益生特性:胆盐耐受性(存活率>87%)、人工胃肠液耐受性(>76%)、无溶血活性,对7种抗生素敏感且对致病菌抑菌作用显著;其发酵上清液的体外自由基清除能力显著高于细胞破碎提取物(P<0.05)。采用苯酚-硫酸法测得未优化条件下L.plantarum JS、L.plantarum LSN、L.plantarum SC、L.plantarum TSJS的EPS产量分别为0.282、0.208、0.215、0.230 mg/mL。IMRAN等[23]采用中心组合设计和响应面法对L.plantarum NTMI05发酵条件进行优化,EPS最大产量达到956 mg/L;VERA PINGITORE等[24]在30 ℃发酵L.plantarum Q823,EPS产量达到133.23 mg/L;AFREEN等[25]将培养基组成和培养温度均纳入优化的范围,EPS产量达到2 064.69 mg/L。后续研究可以考虑通过发酵条件优化和分子生物学技术手段,进一步探索新的高效产糖策略;此外4株植物乳植杆菌的生物活性方面(降血糖、降血脂、抗炎和减肥等)还需要结合体内外实验进行深入研究。综上所述,本研究筛选得到的4株植物乳植杆菌均具有良好的胃肠道适应性、安全性与抗氧化活性,为开发西北特色功能性发酵食品及发酵制剂提供了优质菌种资源和理论依据。
[1] 官小凤,钟晓霞,韩凯,等.植物乳杆菌cqf-43胞外多糖对小鼠生长和肠道健康的影响[J].动物营养学报,2025,37(5):3425-3441.GUAN X F,ZHONG X X,HAN K,et al.Effects of Lactobacillus plantarum cqf-43 exopolysaccharides on growth and intestinal health of mice[J].Chinese Journal of Animal Nutrition,2025,37(5):3425-3441.
[2] 张文静,毛咏荷,李宁,等.酸羊乳发酵及其健康功效研究进展[J].中国乳品工业,2024,52(2):38-45.ZHANG W J,MAO Y H,LI N,et al.Research advance on fermentation of goat milk and its health beneficial effects[J].China Dairy Industry,2024,52(2):38-45.
[3] HUANG R J,WU F,ZHOU Q,et al.Lactobacillus and intestinal diseases:Mechanisms of action and clinical applications[J].Microbiological Research,2022,260:127019.
[4] 黄晓宇,韩瑨,高雅茹,等.植物乳杆菌胞外多糖的研究进展[J].食品与发酵工业,2024,50(13):315-322.HUANG X Y,HAN J,GAO Y R,et al.Research progress of exopolysaccharide from Lactiplantibacillus plantarum[J].Food and Fermentation Industries,2024,50(13):315-322.
[5] DEDHIA N,MARATHE S J,SINGHAL R S.Food polysaccharides:A review on emerging microbial sources,bioactivities,nanoformulations and safety considerations[J].Carbohydrate Polymers,2022,287:119355.
[6] YANG Y J,JIANG G Y,TIAN Y Q.Biological activities and applications of exopolysaccharides produced by lactic acid bacteria:A mini-review[J].World Journal of Microbiology &Biotechnology,2023,39(6):155.
[7] 黄承敏,肖茜,王蓉蓉,等.一株高产胞外多糖乳酸菌的分离鉴定及其产胞外多糖的研究[J].中国酿造,2019,38(1):80-83.HUANG C M,XIAO Q,WANG R R,et al.Isolation and identification of a lactic acid bacteria with high-yield extracellular polysaccharide and their production of extracellular polysaccharide[J].China Brewing,2019,38(1):80-83.
[8] 檀茜倩,麻冰玉,程笑笑,等.一株泡菜中分离高产胞外多糖植物乳杆菌的益生特性分析[J/OL].中国食品学报,2024.https://link.cnki.net/urlid/11.4528.ts.20241111.1737.009.TAN X Q,MA B Y,CHENG X X,et al.Probiotic properties of Lactobacillus plantarum PC715 with high exopolysaccharides(EPS) production isolated from pickled vegetables[J/OL].Journal of Chinese Institute of Food Science and Technology,2024.https://link.cnki.net/urlid/11.4528.ts.20241111.1737.009.
[9] ZHENG X,LIANG Q,ZHAO B T,et al.Whole genome sequencing and analysis of probiotic characteristics for Lactiplantibacillus plantarum EL2 isolated from yak yogurt[J].LWT,2024,198:116039.
[10] 王鑫,江宁,张煜,等.自然发酵虾酱中屎肠球菌的分离、鉴定及体外益生特性分析[J].食品与发酵工业,2025,51(1):136-142.WANG X,JIANG N,ZHANG Y,et al.Isolation and identification of Enterococcus faecium in naturally fermented shrimp sauce and in vitro probiotics properties[J].Food and Fermentation Industries,2025,51(1):136-142.
[11] SADEGHI M,PANAHI B,MAZLUMI A,et al.Screening of potential probiotic lactic acid bacteria with antimicrobial properties and selection of superior bacteria for application as biocontrol using machine learning models[J].LWT,2022,162:113471.
[12] KIM H,KIM J S,KIM Y,et al.Antioxidant and probiotic properties of lactobacilli and bifidobacteria of human origins[J].Biotechnology and Bioprocess Engineering,2020,25(3):421-430.
[13] LIN X N,XIA Y J,YANG Y J,et al.Probiotic characteristics of Lactobacillus plantarum AR113 and its molecular mechanism of antioxidant[J].LWT,2020,126:109278.
[14] ADESULU-DAHUNSI A T,JEYARAM K,SANNI A I.Probiotic and technological properties of exopolysaccharide producing lactic acid bacteria isolated from cereal-based Nigerian fermented food products[J].Food Control,2018,92:225-231.
[15] 徐晶晶,于俊娟,严浩东,等.母婴来源植物乳杆菌的体外益生特性及安全性评价[J].食品与发酵工业,2025,51(6):144-151.XU J J,YU J J,YAN H D,et al.Evaluation of in vitro probiotic characteristics and safety of Lactobacillus plantarum isolated from breast milk and infant feces[J].Food and Fermentation Industries,2025,51(6):144-151.
[16] Clinical and Laboratory Standards Institute (CLSI).Performance standards for antimicrobial susceptibility testing[S].Wayne:CLSI,2017:64-67.
[17] HU X Y,PANG X,WANG P G,et al.Isolation and characterization of an antioxidant exopolysaccharide produced by Bacillus sp.S-1 from Sichuan Pickles[J].Carbohydrate Polymers,2019,204:9-16.
[18] 谢林林,曹瑾,赵玉琪,等.青海牦牛源益生菌分离、鉴定及其益生特性的研究[J].动物营养学报,2025,37(1):658-671.XIE L L,CAO J,ZHAO Y Q,et al.Study on isolation,identification and probiotic properties of Qinghai yak derived probiotics[J].Chinese Journal of Animal Nutrition,2025,37(1):658-671.
[19] SALIBA L,ZOUMPOPOULOU G,ANASTASIOU R,et al.Probiotic and safety assessment of Lactobacillus strains isolated from Lebanese Baladi goat milk[J].International Dairy Journal,2021,120:105092.
[20] SHARMA C,SINGH B P,THAKUR N,et al.Antibacterial effects of Lactobacillus isolates of curd and human milk origin against food-borne and human pathogens[J].3 Biotech,2017,7(1):31.
[21] LIU X,HOU R L,XU K Q,et al.Extraction,characterization and antioxidant activity analysis of the polysaccharide from the solid-state fermentation substrate of Inonotus hispidus[J].International Journal of Biological Macromolecules,2019,123:468-476.
[22] LUO Y L,CAO N X,HUANG L L,et al.Structural characterization,and antioxidant,hypoglycemic and immunomodulatory activity of exopolysaccharide from Sanghuangporus sanghuang JM-1[J].Molecules,2024,29(19):4564.
[23] IMRAN M Y M,REEHANA N,JAYARAJ K A,et al.Statistical optimization of exopolysaccharide production by Lactobacillus plantarum NTMI05 and NTMI20[J].International Journal of Biological Macromolecules,2016,93:731-745.
[24] VERA PINGITORE E,PESSIONE A,FONTANA C,et al.Comparative proteomic analyses for elucidating metabolic changes during EPS production under different fermentation temperatures by Lactobacillus plantarum Q823[J].International Journal of Food Microbiology,2016,238:96-102.
[25] AFREEN A,AHMED Z,KHALID N,et al.Optimization and cholesterol-lowering activity of exopolysaccharide from Lactiplantibacillus paraplantarum NCCP 962[J].Applied Microbiology and Biotechnology,2023,107(4):1189-1204.